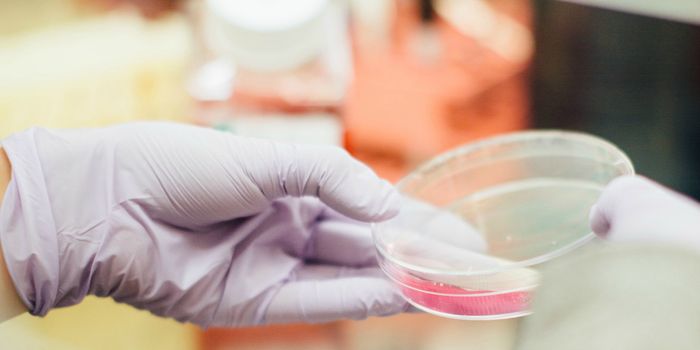
In New Jersey, Medical Marijuana Patients Can't Be Fired for Drug Tests

Medicinal Marijuana
Medical marijuana, or medical cannabis, is a class of therapeutic whose active ingredients include compounds called cannabinoids. Medical marijuana is typically prescribed by physicians to treat patients for a wide range of conditions including nausea, pain, neurological conditions, depression, and anxiety.
-
MAR 20, 2020Cannabis SciencesIn times of high anxiety, uncertainty and home quarantine, stocking up on cannabis in legal states seems almost as popul ...Written By: Annie LennonMAR 20, 2020Health & MedicineA new analysis of cannabis health risks and benefits reinforces the complexity of this drug, proving that health and ris ...MAR 16, 2020Cannabis SciencesAs the legalization of medical cannabis increases in the U.S. and around the globe, its effects on a variety of conditio ...Written By: Julia TraversMAR 13, 2020Health & MedicineThe House Veterans’ Affairs Committee recently advanced two bills relating to veteran use of medical marijuana.&nb ...MAR 12, 2020Cannabis SciencesThirty-three states, Washington D.C., Guam, Puerto Rico and the U.S. Virgin Islands now have a comprehensive, publicly a ...Written By: Julia TraversMAR 11, 2020Cannabis SciencesAs cannabis is becoming more and more popular in the US and beyond, more and more attention is being directed to its lon ...Written By: Annie LennonMAR 07, 2020Cannabis SciencesWhether or not someone enjoys the effects of cannabis tends to depend on how it makes them feel. For example, although f ...Written By: Annie LennonMAR 05, 2020Cannabis SciencesPeople over 50 are the fastest-growing group of cannabis users. As journalist Alex Halperin pointed out in The Guardian, ...Written By: Julia TraversMAR 05, 2020Cannabis SciencesCannabis is one of the oldest known psychoactive drugs. Used in cultures around the world for thousands of years for var ...Written By: Annie LennonMAR 04, 2020Cannabis SciencesSmoking marijuana is known to have multiple side effects. From getting the munchies to paranoia and memory problems, it ...Written By: Annie LennonMAR 03, 2020Cannabis SciencesAlthough cannabis is increasingly recognized for its medicinal properties, it should only be used after considering its ...Written By: Annie LennonFEB 28, 2020Cannabis SciencesNew research has found that children and teenagers suffering from epilepsy had significantly better seizure control when ...Written By: Annie LennonFEB 25, 2020Cannabis SciencesFollowing its legalization, cannabis and its products have become increasingly popular- and not just among young people. ...Written By: Annie LennonFEB 25, 2020Cannabis SciencesWhen a person receives a medical marijuana card, are they good to go, anywhere in the U.S.? No -- it turns out, it can b ...Written By: Julia TraversFEB 23, 2020Cannabis SciencesFollowing the legalization of cannabis use, products derived from the plant are becoming more and more popular- especial ...Written By: Annie LennonFEB 19, 2020Cannabis SciencesSmoking is well-known as a bad health habit. Although not necessarily as detrimental as smoking cigarettes, smoking cann ...Written By: Annie LennonFEB 12, 2020Cannabis SciencesCannabis use can carry a variety of benefits and risks for recreational consumers, patients, doctors and businesses. And ...Written By: Julia TraversFEB 12, 2020Cannabis SciencesSmoking marijuana is known to make people forgetful. Now however, research has shown that smoking the substance may also ...Written By: Annie LennonFEB 10, 2020Cannabis SciencesColorado was one of the first two states in the US, together with Washington, to legalize recreational marijuana in 2012 ...Written By: Annie LennonFEB 07, 2020Cannabis SciencesWhile recreational marijuana remains illegal in Louisiana, the state has made some provisions for medical marijuana use, ...Written By: Julia TraversFEB 07, 2020Health & MedicineUnder federal law, cannabis is illegal and considered a class 1 drug, meaning that it is perceived to have no medical va ...FEB 05, 2020Cannabis SciencesRecreational marijuana use becomes increasingly common as legalization spreads across the country. That includes women w ...Written By: Kara MarkerJAN 31, 2020Health & MedicineA new study published in BMJ Supportive & Palliative Care suggests that medical marijuana may not aid slee ...JAN 29, 2020Cannabis SciencesThe Sicilian government will now foot the bill for many patients using medical cannabis. Sicily’s top health admin ...Written By: Julia Travers
MAR 20, 2020
Cannabis Sciences
In times of high anxiety, uncertainty and home quarantine, stocking up on cannabis in legal states seems almost as popul
...
Written By:
Annie Lennon
MAR 20, 2020
Health & Medicine
A new analysis of cannabis health risks and benefits reinforces the complexity of this drug, proving that health and ris
...
MAR 16, 2020
Cannabis Sciences
As the legalization of medical cannabis increases in the U.S. and around the globe, its effects on a variety of conditio
...
Written By:
Julia Travers
MAR 13, 2020
Health & Medicine
The House Veterans’ Affairs Committee recently advanced two bills relating to veteran use of medical marijuana.&nb
...
MAR 12, 2020
Cannabis Sciences
Thirty-three states, Washington D.C., Guam, Puerto Rico and the U.S. Virgin Islands now have a comprehensive, publicly a
...
Written By:
Julia Travers
MAR 11, 2020
Cannabis Sciences
As cannabis is becoming more and more popular in the US and beyond, more and more attention is being directed to its lon
...
Written By:
Annie Lennon
MAR 07, 2020
Cannabis Sciences
Whether or not someone enjoys the effects of cannabis tends to depend on how it makes them feel. For example, although f
...
Written By:
Annie Lennon
MAR 05, 2020
Cannabis Sciences
People over 50 are the fastest-growing group of cannabis users. As journalist Alex Halperin pointed out in The Guardian,
...
Written By:
Julia Travers
MAR 05, 2020
Cannabis Sciences
Cannabis is one of the oldest known psychoactive drugs. Used in cultures around the world for thousands of years for var
...
Written By:
Annie Lennon
MAR 04, 2020
Cannabis Sciences
Smoking marijuana is known to have multiple side effects. From getting the munchies to paranoia and memory problems, it
...
Written By:
Annie Lennon
MAR 03, 2020
Cannabis Sciences
Although cannabis is increasingly recognized for its medicinal properties, it should only be used after considering its
...
Written By:
Annie Lennon
FEB 28, 2020
Cannabis Sciences
New research has found that children and teenagers suffering from epilepsy had significantly better seizure control when
...
Written By:
Annie Lennon
FEB 25, 2020
Cannabis Sciences
Following its legalization, cannabis and its products have become increasingly popular- and not just among young people.
...
Written By:
Annie Lennon
FEB 25, 2020
Cannabis Sciences
When a person receives a medical marijuana card, are they good to go, anywhere in the U.S.? No -- it turns out, it can b
...
Written By:
Julia Travers
FEB 23, 2020
Cannabis Sciences
Following the legalization of cannabis use, products derived from the plant are becoming more and more popular- especial
...
Written By:
Annie Lennon
FEB 19, 2020
Cannabis Sciences
Smoking is well-known as a bad health habit. Although not necessarily as detrimental as smoking cigarettes, smoking cann
...
Written By:
Annie Lennon
FEB 12, 2020
Cannabis Sciences
Cannabis use can carry a variety of benefits and risks for recreational consumers, patients, doctors and businesses. And
...
Written By:
Julia Travers
FEB 12, 2020
Cannabis Sciences
Smoking marijuana is known to make people forgetful. Now however, research has shown that smoking the substance may also
...
Written By:
Annie Lennon
FEB 10, 2020
Cannabis Sciences
Colorado was one of the first two states in the US, together with Washington, to legalize recreational marijuana in 2012
...
Written By:
Annie Lennon
FEB 07, 2020
Cannabis Sciences
While recreational marijuana remains illegal in Louisiana, the state has made some provisions for medical marijuana use,
...
Written By:
Julia Travers
FEB 07, 2020
Health & Medicine
Under federal law, cannabis is illegal and considered a class 1 drug, meaning that it is perceived to have no medical va
...
FEB 05, 2020
Cannabis Sciences
Recreational marijuana use becomes increasingly common as legalization spreads across the country. That includes women w
...
Written By:
Kara Marker
JAN 31, 2020
Health & Medicine
A new study published in BMJ Supportive & Palliative Care suggests that medical marijuana may not aid slee
...
JAN 29, 2020
Cannabis Sciences
The Sicilian government will now foot the bill for many patients using medical cannabis. Sicily’s top health admin
...
Written By:
Julia Travers